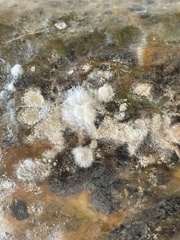

Sclerotinia sclerotiorum: taxon details and analytics
- Domain
- Kingdom
- Fungi
- Phylum
- Ascomycota
- Class
- Leotiomycetes
- Order
- Helotiales
- Family
- Sclerotiniaceae
- Genus
- Sclerotinia
- Species
- Sclerotinia sclerotiorum
- Scientific Name
- Sclerotinia sclerotiorum
Summary description from Wikipedia:
Sclerotinia sclerotiorum
Sclerotinia sclerotiorum is a plant pathogenic fungus and can cause a disease called white mold if conditions are conducive. S. sclerotiorum can also be known as cottony rot, watery soft rot, stem rot, drop, crown rot and blossom blight. A key characteristic of this pathogen is its ability to produce black resting structures known as sclerotia and white fuzzy growths of mycelium on the plant it infects. These sclerotia give rise to a fruiting body in the spring that produces spores in a sac which is why fungi in this class are called sac fungi (Ascomycota). This pathogen can occur on many continents and has a wide host range of plants. When S. sclerotiorum is onset in the field by favorable environmental conditions, losses can be great and control measures should be considered.
...Sclerotinia sclerotiorum in languages:
- Afrikaans
- Stamvrot
- Afrikaans
- Snotkop
- Bokmål
- storknollet råtesopp
- Chinese
- 核盤菌
- Czech
- hlízenka hlíznatá
- English
- white mold
- English
- cottony rot
- English
- watery soft rot
- English
- stem rot
- English
- stem drop
- English
- crown rot
- English
- blossom blight
- Finnish
- pahkahome
- Lithuanian
- Paprastoji sklerotinija
- Swedish
- rotfruktsröta
Images from inaturalist.org observations:
We recommend you sign up for this excellent, free service.